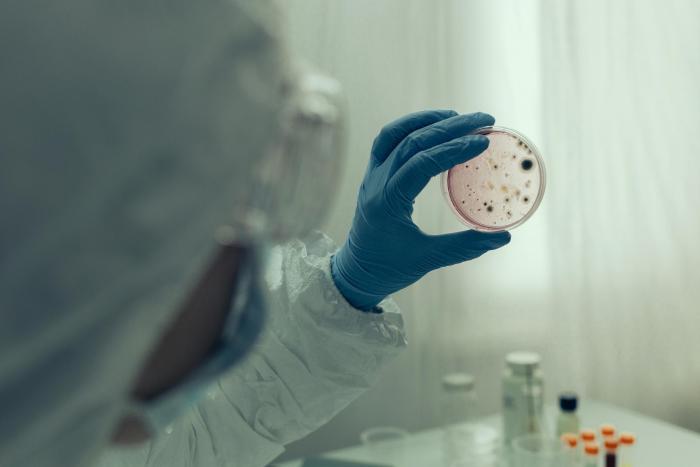
course-premium

Maestría en Epidemiología
Master
Online
*Precio Orientativo
Importe original en COP:
$ 6.660.000

¿Necesitas un coach de formación?
Te ayudará a comparar y elegir el mejor curso para ti y a financiar tu matrícula en cómodos plazos.
Tu formación hace la diferencia
-
Tipología
Master
-
Metodología
Online
Los profundos cambios sociodemográficos y migratorios hacen necesaria una mayor preparación académica; en AREANDINA asumimos el reto de mejorar el perfil de los profesionales en el sector salud y para ello la Maestría en Epidemiología brinda herramientas conceptuales y tecnológicas que permitan analizar evidencias para la toma de decisiones de las problemáticas en salud, a nivel individual y colectivo, partiendo de los fundamentos propios de la vigilancia epidemiológica y la investigación, con el objetivo de optimizar las políticas públicas para tener una mejor capacidad de respuesta.
Instalaciones y fechas
Ubicación
Inicio
Inicio
A tener en cuenta
PERFIL PROFESIONAL
Serás el encargado de diseñar estudios epidemiológicos desde diferentes enfoques, interpretarás datos epidemiológicos y analizarás sistemáticamente la situación y las tendencias de la salud poblacional, evaluando las características y los factores de riesgo medioambientales; estarás en capacidad de identificar la pertinencia, uso e implementación de las tecnologías en salud para optimizar tus resultados.
Si eres un profesional deseoso de contribuir al progreso del sector salud en Colombia y en el mundo, eres consciente de la necesidad de conocer en profundidad las causas de la morbilidad y la mortalidad, eres una persona crítica y sensible frente a las desigualdades territoriales y estás motivado hacia el aprendizaje de las Tecnologías de la Información y la Comunicación, en AREANDINA estamos buscando a alguien como tú, para brindarte las herramientas necesarias para elevar tu perfil profesional, transformándote en un magíster en epidemiología líder e innovador que sea capaz de dar respuestas a las necesidades del sector.
Título Magíster en Epidemiología
SNIES 108413
Resolución No. 11693 del 7 de noviembre del 2019
Opiniones
Logros de este Centro
Todos los cursos están actualizados
La valoración media es superior a 3,7
Más de 50 opiniones en los últimos 12 meses
Este centro lleva 16 años en Emagister.
Materias
- Vigilancia
- Epidemiología
- Bioestadística
- Bases de datos
- Profundización
- Salud Pública
- Vigilancia epidemiológica
- Bioestadística avanzada
- Epidemiología aplicada
- Manejo de bases de datos epidemiológicos
Temario
Primer Semestre
- Seminario de Investigación I
- Bioestadística y Demografía
- Salud Pública y Vigilancia Epidemiológica
- Fundamentos de Epidemiología
- Electiva I
Segundo Semestre
- Bioestadística Aplicada
- Epidemiología Aplicada I
- Análisis y Manejo de Bases de Datos Epidemiológicos
- Seminario de Investigación II
- Electiva II
Tercer Semestre
- Profundización
- Seminario de Investigación III
- Bioestadística Avanzada
- Epidemiología Aplicada II
- Electiva III
¿Necesitas un coach de formación?
Te ayudará a comparar y elegir el mejor curso para ti y a financiar tu matrícula en cómodos plazos.
Maestría en Epidemiología
*Precio Orientativo
Importe original en COP:
$ 6.660.000






